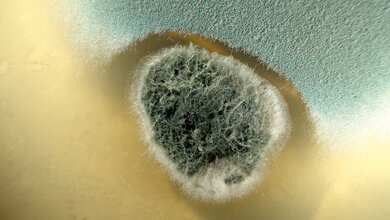
Foto von Stachybotris und Aspergillus fumigatus
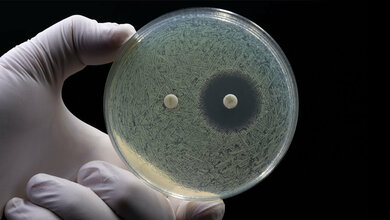
Test auf Antibiotikaresistenz

Bakterien und andere Mikroorganismen bilden eine Reihe von Stoffen (sogenannte Sekundärmetabolite), die zwar für ihr Überleben nicht zwingend notwendig sind, doch sie verschaffen ihnen in ihrer Umwelt Vorteile. Sie dienen zum Beispiel der Kommunikation untereinander oder der Verteidigung gegen andere Organismen. Damit könnten sie auch in der Medizin als potenzielle Wirkstoffe gegen Bakterien und Pilze eingesetzt werden. „Die Vielfalt dieser Verbindungen ist bei weitem noch nicht aufgeklärt“, sagt Prof. Dr. Dirk Tischler von der Ruhr-Universität Bochum, der zusammen mit Prof. Dr. Sandy Schmidt von der Universität Groningen das Team leitet. Die Forschenden hoffen, solche Naturstoffe selbst als bioaktive Verbindungen in Medikamenten nutzen oder als Blaupause zur Synthese neuer Wirkstoffe heranziehen zu können. „Auch Penicillin ist einer dieser Sekundärmetabolite“, verdeutlicht Tischler.
Kutzneride standen im Mittelpunkt
Eine besonders interessante Stoffgruppe unter diesen Verbindungen sind die sogenannten Kutzneride: Sie wirken sowohl gegen einige Pilze als auch gegen Gram-positive Bakterien. Ihre Wirksamkeit wird durch funktionelle Gruppen bestimmt. In der aktuellen Arbeit standen solche Kutzneride im Mittelpunkt, deren funktionelle Gruppe eine Bindung zwischen zwei Stickstoffatomen besitzt. Die Forschenden bezeichnen diese funktionelle Gruppe als Hydrazine. „Solche Verbindungen kommen in der Natur zwar vor“, so Tischler, „uns ist es aber gelungen, sie und ihre Umgebung gezielt zu beeinflussen.“ Die Forschenden identifizierten bislang unbekannte Enzyme, welche die Stickstoff-Stickstoff-Verbindung initiieren und die Atome verknüpfen. Mittels Mutagenese optimierten sie die Enzyme noch, sodass sie verschiedene Substrate umsetzen konnten. Die verschiedenen Enzyme wurden schließlich als Kaskade zusammengeführt. „Wir konnten zeigen, dass nicht natürliche Substrate in 5- und 6- zyklische Ringstrukturen inklusive eine Stickstoff-Stickstoff-Bindung umgesetzt werden konnten“, berichtet Tischler. Dabei sei es gelungen, in einigen Fällen ein chirales Zentrum einzufügen, was für spätere Synthesen von pharmazeutischen Stoffen entscheidend sei.
Quelle: idw/RUB
Artikel teilen